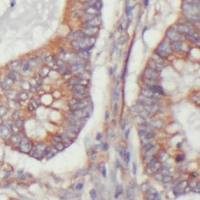
兔多克隆 AGXT2L2 抗体丨anti- AGXT2L2 antibody

相关产品推荐更多 >
兔多克隆 AGXT2L2 抗体丨anti- AGXT2L2 antibody
¥892.50
Rabbit anti-TriMethyl-Histone H4(Lys20) Polyclonal Antibody【兔抗三甲基组蛋白H4(Lys20)多克隆抗体】- abs158645
¥2300
Alexa Fluor® 488 anti-mouse TCR β chain
¥3267
CD34 Antibody (BF750) 抗体,orb1586209,Biorbyt
¥4796
RAR gamma Rabbit pAb, APC-Cy5.5 conjugated(bs-6218R-APC-Cy5.5)-100ul
¥2980
万千商家帮你免费找货
0 人在求购买到急需产品
- 详细信息
- 技术资料
- 抗体名:
anti- ADH1B antibody
- 抗体英文名:
anti- ADH1B antibody
- 应用范围:
ELISA, WB
- 宿主:
Rabbit
- 适应物种:
Human, Mouse, Rat
- 保质期:
12 months -20℃
- 目录编号:
FNab00162
- 级别:
科研
- 库存:
100
- 供应商:
武汉琼格生物科技有限公司
- 克隆性:
polyclonal
- 保存条件:
PBS with 0.02% sodium azide and 50% glycerol pH 7.3,-20℃ for 12 months(Avoid repeated freeze / thaw cycles.)
- 形态:
liquid
- 亚型:
IgG
- 免疫原:
alcohol dehydrogenase 1B(class I), beta polypeptide
- 规格:
50µg/100µg
| 规格: | 50µg | 产品价格: | ¥892.5 |
|---|---|---|---|
| 规格: | 100µg | 产品价格: | ¥1487.5 |

点击查看官网产品详细介绍:兔多克隆 ADH1B 抗体丨anti- ADH1B antibody可以用于Human, Mouse, Rat实验ELISA, WB
---------------------------------------------------------------------------------------------------------
在线联系更方便:时燕, 电话同微信:13657207535 QQ:1214415300
---------------------------------------------------------------------------------------------------------
产品介绍
| 产品名称 | anti- ADH1B antibody | |
| 货号 | FNab00162 | |
| 规格 | 100µg | |
| 纯化方法 | Immunogen affinity purified | |
| 纯度 | ≥95% as determined by SDS-PAGE | |
| 宿主 | Rabbit | |
| 克隆性 | polyclonal | |
| 亚型 | IgG | |
| 存储 | PBS with 0.02% sodium azide and 50% glycerol pH 7.3,-20℃ for 12 months(Avoid repeated freeze / thaw cycles.) | |
| 免疫原 | alcohol dehydrogenase 1B(class I), beta polypeptide | |
| 分子量 | 40 kDa | |
| Uniprot ID | P00325 | |
| 适用种属 | Human, Mouse, Rat | |
| 验证应用 | ELISA, WB | |
| 建议稀释比例 | WB: 1:500-1:5000 | |
| 图片 | IHC图片 |  |
| WB图片 |  | 兔多克隆 ADH1B 抗体丨anti- ADH1B antibody仅供科研使用 仅供科研使用
|
武汉菲恩生物科技有限公司(Wuhan Fine Biotech Co., Ltd.)面向国际市场专业研发、生产和销售ELISA试剂盒、抗体、重组蛋白及相关试剂。公司坐落于中国光谷生物城,建有现代化的研发中心和标准的生产车间,已整体通过ISO 9001:2015质量管理体系认证,获得高新技术企业、3551人才、瞪羚企业、科技小巨人等多项荣誉;公司建有实验动物房、配备先进的实验仪器,以保证产品的品质和实验研究的准确可靠性。产品在免疫学、信号转导、代谢、神经科学等领域内都有最前沿科学文献发表,被国内外多所大学、研究机构和药学平台使用并发表文献多达1000多次。公司凭借优异的产品和完善的服务体系受到广大国内外用户的青睐和认可。FineTest®科研好帮手,专业生产商
FineTest®品牌保障:
1、质量保证:产品质量稳定,每批次产品必须通过QA、QC检测才可出库;
2、实力强大:ISO9001:2015认证,标准实验室、研发中心,动物房,高新技术企业;
3、技术支持:技术部5*8小时技术问题及时解答;
4、服务周到:发货及时,三个工作日顺丰快递;
5、售后无忧:产品质量问题包退包换,售后邮箱:sales2@fn-test.com
FineTest®抗体产品优势
1、种类齐全:鼠单抗,兔多抗一万余种经过验证的抗体,内参标签抗体、小分子抗体、对照抗体;
2、多种标记二抗:山羊、猴、鸡、大小鼠、仓鼠、兔、绵羊、人、牛等多种属100余种标记二抗,HRP、AP、Biotin、FITC、Alexa Fluor 488、Cyc、荧光素等标记物;
3、验证多种实验:可应用于ELISA、WB、IHC、IF、IP、FC等实验应用,进行了广泛的交叉实验;
FineTest®研发、生产科研产品:
ELISA试剂盒:研发产品涉及常规种属:人、大鼠、小鼠;也有稀有种属:豚鼠、仓鼠、兔、鸡、猪、犬、猴、马、牛、山羊、绵羊、通用型等;具有高灵敏度、严格控制的批间、批内差等特点深受国外客户认可;
抗体:兔多抗、鼠单抗种类丰富,一抗1万余种,二抗100多种;具有高亲合力和特异性;
重组蛋白:多项发明专利,原核表达系统、真核表达系统稳定表达3000余种蛋白。
---------------------------------------------------------------------------------------------------------

风险提示:丁香通仅作为第三方平台,为商家信息发布提供平台空间。用户咨询产品时请注意保护个人信息及财产安全,合理判断,谨慎选购商品,商家和用户对交易行为负责。对于医疗器械类产品,请先查证核实企业经营资质和医疗器械产品注册证情况。
 技术资料
技术资料暂无技术资料 索取技术资料
兔多克隆 ADH1B 抗体丨anti- ADH1B antibody
¥892.50 - 1487.50




